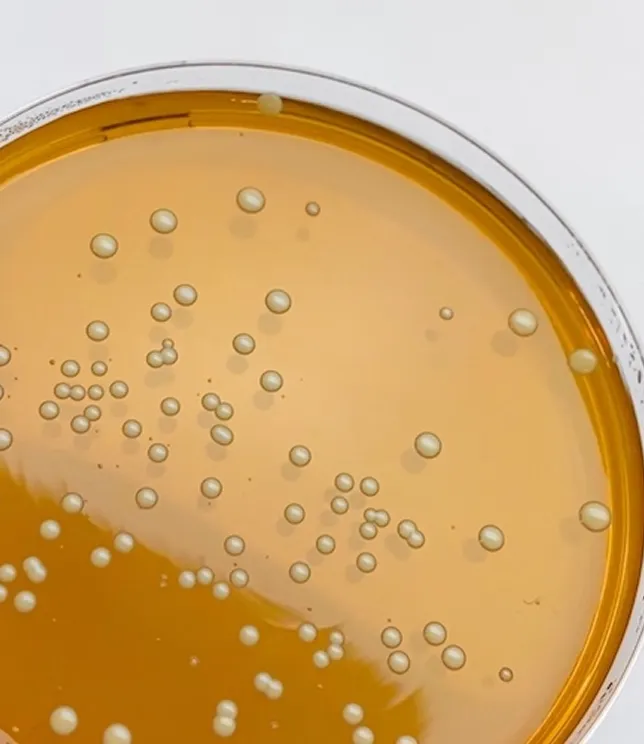
Szalka Petriego z hodowlą bakterii &ndash; badania nad skutecznością probiotyk&oacute;w YUN Probiotherapy

HUMAN MICROBIOME PROJECT
Do niedawna mikrobiom człowieka był obszarem stosunkowo mało zbadanym. Wpływ mikrobiomu na rozwój, fizjologię, odporność i metabolizm człowieka był praktycznie nieznany. W 2008 roku amerykański Narodowy Instytut Zdrowia (NIH) zainicjował projekt Human Microbiome Project (HMP), którego celem jest identyfikacja mikroorganizmów bytujących w ludzkim ciele oraz analiza ich wpływu na zdrowie i choroby.